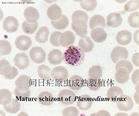
腸外原蟲

分類
瘧原蟲屬於真球蟲目(Eucoccidiida)、瘧原蟲科(Plasmodidae)、瘧原蟲屬(Plasmodium),是瘧疾(malaria)的病原體。瘧原蟲種類繁多,寄生於人類的瘧原蟲有4種,即間日瘧原蟲[Plasmodium vivax(Grassi and Felletti,1890) Labbe,1899]、惡性瘧原蟲[Plasmodium falciparum(Welch,1897) Schaudinn,1902]、三日瘧原蟲[Plasmodium malariae (Laveran,1881) Grassi and Felletti,1890]和卵形瘧原蟲[Plasmodium OVALE Stephens,1922],分別引起間日瘧、惡性瘧、三日瘧和卵形瘧。在我國主要有間日瘧原蟲和惡性瘧原蟲,三日瘧原蟲少見,卵形瘧原蟲罕見。
形態
瘧原蟲
瘧原蟲1.瘧原蟲在紅細胞內發育各期的形態 瘧原蟲在紅細胞內生長、發育、繁殖,形態變化很大。一般分為三個主要發育期。
(1)滋養體(trophozoite):為瘧原蟲在紅細胞內攝食和生長、發育的階段。按發育先後,滋養體有早、晚期之分。早期滋養體胞核小,胞質少,中間有空泡,蟲體多呈環狀,故又稱之為環狀體(ring form)。以後蟲體長大,胞核亦增大,胞質增多,有時伸出偽足,胞質中開始出現瘧色素(malarial pigment)。間日瘧原蟲和卵形瘧原蟲寄生的紅細胞可以變大、變形,顏色變淺,常有明顯的紅色薛氏點(Schuffner’s dots);被惡性瘧原蟲寄生的紅細胞有粗大的紫褐色茂氏點(Maurer’s dots);被三日瘧原蟲寄生的紅細胞可有齊氏點(Ziemann’s dots)。此時稱為晚期滋養體,亦稱大滋養體。
(2)裂殖體(schizont):晚期滋養體發育成熟,核開始分裂後即稱為裂殖體。核經反復分裂,最後胞質隨之分裂,每一個核都被部分胞質包裹,成為裂殖子(merozoite),早期的裂殖體稱為未成熟裂殖體,晚期含有一定數量的裂殖子且瘧色素已經集中成團的裂殖體稱為成熟裂殖體。
(3)配子體(gametocyte):瘧原蟲經過數次裂體增殖後,部分裂殖子侵入紅細胞中發育長大,核增大而不再分裂,胞質增多而無偽足,最後發育成為圓形、卵圓形或新月形的個體,稱為配子體;配子體有雌、雄(或大小)之分:雌(大)配子體蟲體較大,胞質緻密,瘧色素多而粗大,核緻密而偏於蟲體一側或居中;雄(小)配子體蟲體較小,胞質稀薄,瘧色素少而細小,核質疏鬆、較大、位於蟲體中央。
2.超微結構
(1)裂殖子:紅細胞內期裂殖子呈卵圓形,有表膜複合膜(pellicular complex)包繞。大小隨蟲種略有不同,平均長1.5µm,平均直徑1µm。
表膜(pellicle)由一質膜和兩層緊貼的內膜組成。質膜厚約7.5µm,內膜厚約15µm,有膜孔。緊靠內膜的下面是一排起於頂端極環(polar ring)並向後部放散的表膜下微管(subpellicular microtubule)。內膜和表膜下微管可能起細胞骨架作用,使裂殖子有硬度。游離的裂殖子的外膜有一厚約20µm表被(surface coat)覆蓋。此表被是電子緻密、堅實的纖絲,在性質上似是蛋白質,可能在對宿主免疫反應的應答中起作用。在裂殖子側面表膜有一胞口(cytostome),紅細胞內期各期原蟲通過胞口攝取宿主細胞漿。
裂殖子頂端是一截頭的圓錐形突起稱為頂突(apical prominence),有三個極環。在此區可見兩個電子緻密的棒狀體(rhoptry)和數個微線體(micronemes)。棒狀體和微線體可能在裂殖子侵入宿主細胞時起作用。裂殖子後部可見一線粒體。內質網很少,但胞漿內有豐富的核糖體。高爾基氏複合體不明顯。裂殖子的核大而圓,位於蟲體後半部,沿核膜可見核孔,未見有核仁。
(2)子孢子:子孢子形狀細長,長約11µm,直徑為1.0µm,常彎曲呈C形或S形,前端稍細,頂端較平,後端鈍圓,體表光滑。子孢子內的細胞器基本上與裂殖子相似。表膜由一外膜、雙層內膜和一層表膜下微管組成。膜下微管自極環向後延伸至核或稍越過核而終止。蟲體的微弱運動可能是膜下微管的伸縮引起的。子孢子的前端頂部有一向內凹入的頂杯(anterior cup)即頂突,在頂突的周圍有3~4個極環。細胞核一個,長形。有一對電子緻密的棒狀體,可能開口於頂環。在核的前方或後方,有數量很多的微線體,呈圓形、卵圓形或長形。
生活史
寄生於人體的4種瘧原蟲生活史基本相同,需要人和按蚊二個宿主。在人體內先後寄生於肝細胞和紅細胞內,進行裂體增殖(schizogony)。在紅細胞內,除進行裂體增殖外,部分裂殖子形成配子體,開始有性生殖的初期發育。在蚊體內,完成配子生殖(gametogony),繼而進行孢子增殖(sporogony)。1.在人體內的發育 分肝細胞內的發育和紅細胞內的發育二個階段:
(1)紅細胞外期(exo-erythrocytic cycle,簡稱紅外期):當唾腺中帶有成熟子孢子(sporozoite)的雌性按蚊刺吸人血時,子孢子隨唾液進入人體,約經30分鐘後隨血流侵入肝細胞,攝取肝細胞內營養進行發育並裂體增殖,形成紅細胞外期裂殖體。成熟的紅細胞外期裂殖體內含數以萬計的裂殖子。裂殖子脹破肝細胞後釋出,一部分裂殖子被巨噬細胞吞噬,其餘部分侵入紅細胞,開始紅細胞內期的發育。間日瘧原蟲完成紅細胞外期的時間約8天,惡性瘧原蟲約6天,三日瘧原蟲為11~12天,卵形瘧原蟲為9天。
目前一般認為間日瘧原蟲和卵形瘧原蟲的子孢子具有遺傳學上不同的兩種類型,即速髮型子孢子(tachysporozoites,TS)和遲髮型子孢子(bradysporozoites,BS)。當子孢子進入肝細胞後,速髮型子孢子繼續發育完成紅細胞外期的裂體增殖,而遲髮型子孢子視蟲株的不同,需經過一段或長或短(數月至年余)的休眠期後,才完成紅細胞外期的裂體增殖。經休眠期的子孢子被稱之為休眠子(hypnozoite)。惡性瘧原蟲和三日瘧原蟲無休眠子。
(2)紅細胞內期(erythrocytic cycle,簡稱紅內期):紅細胞外期的裂殖子從肝細胞釋放出來,進入血流後很快侵入紅細胞。裂殖子侵入紅細胞的過程包括以下步驟:①裂殖子通過特異部位識別和附著於紅細胞膜表面受體;②紅細胞廣泛性變形,紅細胞膜在環繞裂殖子處凹入形成納蟲空泡;③裂殖子入侵完成後納蟲空泡密封。在入侵過程中裂殖子的細胞表被脫落於紅細胞中。
侵入的裂殖子先形成環狀體,攝取營養,生長發育,經大滋養體、未成熟裂殖體,最後形成含有一定數量裂殖子的成熟裂殖體。紅細胞破裂後,裂殖子釋出,其中一部分被巨噬細胞吞噬,其餘再侵入其他正常紅細胞,重複其紅細胞內期的裂體增殖過程(圖11—3)。完成一代紅細胞內期裂體增殖,間日瘧原蟲約需48小時,惡性瘧原蟲約需36~48小時,三日瘧原蟲約需72小時,卵形瘧原蟲約需48小時。惡性瘧原蟲的早期滋養體在外周血液中經十幾小時的發育後,逐漸隱匿於微血管、血竇或其他血流緩慢處,繼續發育成晚期滋養體及裂殖體,這2個時期在外周血液中一般不易見到。
瘧原蟲經幾代紅細胞內期裂體增殖後,部分裂殖子侵入紅細胞後不再進行裂體增殖而是發育成雌、雄配子體。惡性瘧原蟲的配子體主要在肝、脾、骨髓等器官的血竇或微血管里發育,成熟後始出現於外周血液中,約在無性體出現後7~10天才見於外周血液中。配子體的進一步發育需在蚊胃中進行,否則在人體內經30~60天即衰老變性而被清除。
4種瘧原蟲寄生於紅細胞的不同發育期,間日瘧原蟲和卵形瘧原蟲主要寄生於網織紅細胞,三日瘧原蟲多寄生於較衰老的紅細胞,而惡性瘧原蟲可寄生於各發育期的紅細胞。
2.瘧原蟲在按蚊體內的發育 當雌性按蚊刺吸病人或帶蟲者血液時,在紅細胞內發育的各期原蟲隨血液入蚊胃,僅雌、雄配子體能在蚊胃內繼續發育,其餘各期原蟲均被消化。在蚊胃內,雄配子體核分裂成4—8塊,胞質也向外伸出4—8條細絲;不久,每一小塊胞核進入一條細絲中,細絲脫離母體,在蚊胃中形成雄配子(male gamete)。雄配子體在蚊胃中遊動,此後,鑽進雌配子(female gamete)體內,受精形成合子(zygote)。合子變長,能動,成為動合子(ookinete)。動合子穿過胃壁上皮細胞或其間隙,在蚊胃基底膜下形成圓球形的卵囊(oocyst)。卵囊長大,囊內的核和胞質反覆分裂進行孢子增殖,從成孢子細胞(sporoblasy)表面芽生子孢子,形成數以萬計的子孢子(sporozoite)。子孢子隨卵囊破裂釋出或由囊壁鑽出,經血淋巴集中於按蚊的涎腺,發育為成熟子孢子。當受染蚊再吸血時,子孢子即可隨唾液進入人體,又開始在人體內的發育。在最適條件下,瘧原蟲在按蚊體內發育成熟所需時間:間日瘧原蟲約為9~10天,惡性瘧原蟲約為10~12天,三日瘧原蟲約為25~28天,卵形瘧原蟲約為16天。
瘧原蟲在蚊體內發育受多種因素影響,諸如配子體的感染性(成熟程度)與活性、密度及雌雄配子體的數量比例,蚊體內生化條件與蚊體對入侵瘧原蟲的免疫反應性,以及外界溫、濕度變化對瘧原蟲蚊期發育的影響。
營養代謝
瘧原蟲可通過表膜的滲透或經胞口以吞飲方式攝取營養。在肝細胞內寄生的紅細胞外期瘧原蟲,以肝細胞的胞質為營養。1.葡萄糖代謝 紅細胞內期瘧原蟲的糖原儲存很少,葡萄糖是瘧原蟲紅細胞內期主要的能量來源。瘧原蟲的寄生使紅細胞膜發生變化,增強了葡萄糖通過膜的主動轉運,或者除去某些抑制轉運的因子,從而使瘧原蟲可源源不斷地從宿主的血漿獲得葡萄糖以供代謝之用。6-磷酸葡萄糖脫氫酶(G6PD)是戊糖磷酸途徑所需要的酶,受染瘧原蟲的紅細胞內G6PD缺乏時,影響瘧原蟲分解葡萄糖,導致蟲體發育障礙。缺乏G6PD的病人對惡性瘧原蟲有選擇抗性是否與此有關尚待進一步研究。
2.蛋白質代謝 瘧原蟲獲得的游離胺基酸主要是來自紅細胞內的血紅蛋白的水解產物,還來自宿主的血漿和紅細胞內的胺基酸庫及有機物碳。血紅蛋白從瘧原蟲胞口被吞入,由胞口基部長出食物泡,胞口孔被膜封閉。血紅蛋白被食物泡內的酸性肽鏈內切酶和氨基肽酶的協同作用消化分解為珠蛋白和血紅素。珠蛋白在酶的作用下再分解為幾種胺基酸以供合成蟲體本身的蛋白質。血紅素最後形成一種複合物即瘧色素。瘧色素不被溶解和吸收而留在食物泡的壁上。在紅細胞內裂體增殖過程中,瘧色素逐漸融合成團,隨著裂體增殖完成後被排入血流。
3.核酸代謝 瘧原蟲沒有從頭合成嘌吟的途徑,僅依靠一個補救途徑利用現成的嘌呤鹼基和核苷。參與嘌呤補救途徑的酶有腺苷酸脫氫酶、嘌呤—核苷磷酸化酶等。
在瘧原蟲的多種生物合成途徑中,對氨基苯甲酸(PABA)、四氫葉酸(THF)等都是很重要的輔助因子。如果宿主的食物中缺乏PABA,則影響THF的生成,其體內寄生的瘧原蟲的生長繁殖發生障礙,感染因而被抑制。
4.脂類代謝 瘧原蟲無脂類儲存,也不能合成脂肪酸與膽固醇,完全依賴於宿主提供,如從宿主血漿中獲得游離脂肪酸和膽固醇,膽固醇對維持瘧原蟲及受染細胞的膜的完整性都具有重要作用。紅細胞內瘧原蟲所需的脂類可由攝入的葡萄糖代謝的產物組成,其中主要為磷脂,磷脂增多與瘧原蟲膜的合成有關。
致病
瘧原蟲的主要致病階段是紅細胞內期的裂體增殖期。致病力強弱與侵入的蟲種、數量和人體免疫狀態有關。1.潛伏期(incubation period) 指瘧原蟲侵入人體到出現臨床症狀的間隔時間,包括紅細胞外期原蟲發育的時間和紅細胞內期原蟲經幾代裂體增殖達到一定數量所需的時間。潛伏期的長短與進入人體的原蟲種株、子孢子數量和機體的免疫力有密切關係。惡性瘧的潛伏期為7~27天;三日瘧的潛伏期為18~35天;卵形瘧的潛伏期為11~16天;間日瘧的短潛伏期株為11~25天,長潛伏期株為6~12個月或更長。對我國河南、雲南、貴州、廣西和湖南等省志願者進行多次感染間日瘧原蟲子孢子的實驗觀察,表明各地均兼有間日瘧長、短潛伏期2種類型,而且二者出現的比例有由北向南短潛伏期比例增高的趨勢。由輸血感染誘發的瘧疾,潛伏期一般較短。
2.瘧疾發作(paroxysm) 瘧疾的一次典型發作表現為寒戰、高熱和出汗退熱三個連續階段。發作是由紅細胞內期的裂體增殖所致,當經過幾代紅細胞內期裂體增殖後,血中原蟲的密度達到發熱閾值(threshold),如間日瘧原蟲為10~500個/µl血,惡性瘧原蟲為500~1300個/µl血。紅細胞內期成熟裂殖體脹破紅細胞後,大量的裂殖子、原蟲代謝產物及紅細胞碎片進入血流,其中一部分被巨噬細胞、中性粒細胞吞噬,刺激這些細胞產生內源性熱原質,它和瘧原蟲的代謝產物共同作用於宿主下丘腦的體溫調節中樞,引起發熱。隨著血內刺激物被吞噬和降解,機體通過大量出汗,體溫逐漸恢復正常,機體進入發作間歇階段。由於紅細胞內期裂體增殖是發作的基礎,因此發作具有周期性,此周期與紅細胞內期裂體增殖周期一致。典型的間日瘧和卵形瘧隔日發作1次;三日瘧為隔2天發作1次;惡性瘧隔36~48小時發作1次。若寄生的瘧原蟲增殖不同步時,發作間隔則無規律,如初發患者。不同種瘧原蟲混合感染時或有不同批次的同種瘧原蟲重複感染時,發作也多不典型。瘧疾發作次數主要取決於患者治療適當與否及機體免疫力增強的速度。隨著機體對瘧原蟲產生的免疫力逐漸增強,大量原蟲被消滅,發作可自行停止。
3.瘧疾的再燃和復發 瘧疾初發停止後,患者若無再感染,僅由於體內殘存的少量紅細胞內期瘧原蟲在一定條件下重新大量繁殖又引起的瘧疾發作,稱為瘧疾的再燃(recrudescence)。再燃與宿主抵抗力和特異性免疫力的下降及瘧原蟲的抗原變異有關。瘧疾復發(relapse)是指瘧疾初發患者紅細胞內期瘧原蟲已被消滅,未經蚊媒傳播感染,經過數周至年余,又出現瘧疾發作,稱復發。關於復發機理目前仍未闡明清楚,其中子孢子休眠學說認為由於肝細胞內的休眠子復甦,發育釋放的裂殖子進入紅細胞繁殖引起的瘧疾發作。惡性瘧原蟲和三日瘧原蟲無遲髮型子孢子,因而只有再燃而無復發。間日瘧原蟲和卵形瘧原蟲既有再燃,又有復發。
4. 貧血(anemia) 瘧疾發作數次後,可出現貧血,尤以惡性瘧為甚。懷孕婦
女和兒童最常見,流行區的高死亡率與嚴重貧血有關。貧血的原因除了瘧原蟲直接破壞紅細胞外,還與下列因素有關:①脾功能亢進,吞噬大量正常的紅細胞。②免疫病理的損害。瘧原蟲寄生於紅細胞時,使紅細胞隱蔽的抗原暴露,刺激機體產生自身抗體,導致紅細胞的破壞。此外宿主產生特異抗體後,容易形成抗原抗體複合物,附著在紅細胞上的免疫複合物可與補體結合,使紅細胞膜發生顯著變化而具有自身免疫原性,並引起紅細胞溶解或被巨噬細胞吞噬。瘧疾患者的貧血程度常超過瘧原蟲直接破壞紅細胞的程度。③骨髓造血功能受到抑制。
5.脾腫大 初發患者多在發作3~4天后,脾開始腫大,長期不愈或反覆感染者,脾腫大十分明顯,可達臍下。主要原因是脾充血和單核—巨噬細胞增生。早期經積極抗瘧治療,脾可恢復正常大小。慢性患者,由於脾包膜增厚,組織高度纖維化,質地變硬,雖經抗瘧根治,也不能恢復到正常。
在非洲或亞洲某些熱帶瘧疾流行區,出現“熱帶巨脾綜合症”,可能是有瘧疾的免疫反應所引起。患者多伴有肝大、門脈高壓、脾功能亢進、巨脾症、貧血等症狀;血中IgM水平增高。
6.兇險型瘧疾 兇險型瘧疾絕大多數由惡性瘧原蟲所致,但間日瘧原蟲引起的腦型瘧國內已有報導。多數學者認為,兇險型瘧疾的致病機制是聚集在腦血管內被瘧原蟲寄生的紅細胞和血管內皮細胞發生粘連,造成微血管阻塞及局部缺氧所致。此型瘧疾多發生於流行區兒童、無免疫力的旅遊者和流動人口。
臨床表現
臨床表現複雜,常見的有腦型和超高熱型,多表現為持續高燒、全身衰竭、意識障礙、呼吸窘迫、多發性驚厥、昏迷、肺水腫、異常出血、黃疸、腎功能衰竭、血紅蛋白尿和惡性貧血等。兇險型瘧疾來勢兇猛,若不能及時治療,死亡率很高。腦型瘧疾(cerebral malaria, CM)大多數發生於惡性瘧患者,但國內已報導由間日瘧引起的,是兒童和無免疫力成人患者的主要死亡原因,臨床上中樞神經系統症狀明顯,如劇烈頭痛、昏迷、譫妄、抽搐、驚厥、體溫高達40~41oC、但個別也有不發熱者。常因昏迷並發感染而死亡。CM的發病機制、學說不一,近年報導是一種多因素參與的免疫病理性疾病。患者體內某些細胞因子、粘附因子和一氧化碳是引起CM發病的重要因素,如過量的TNF-α、IFN-γ等細胞因子激活內皮細胞表達粘附受體,增強內皮細胞的粘附性,使受染紅細胞粘附與腦的微血管內,導致血管阻塞,製成腦局部缺氧和營養耗竭而引起腦併發症。
在不同瘧疾流行區,兇險型瘧疾的高發人群和臨床表現都很不同。在穩定的高度瘧疾流行區,出生幾個月的嬰兒和5歲以下的幼童是兇險型瘧疾的高發人群,主要的臨床表現是惡性貧血。在中度瘧疾流行區,腦型瘧疾和代謝性酸中毒是兒童常見的兇險型瘧疾。在低度瘧疾流行區,急性腎衰竭、黃疸和肺水腫是成年人常見的臨床表現,貧血、低血糖症和驚厥在兒童中比較多見,而腦型瘧疾和代謝性酸中毒在所有的年齡組都可有。
免疫
1.先天抵抗力(natural resistance) 這種抵抗力與宿主的瘧疾感染史無關,而與宿主的種類和遺傳特性有關。如90%以上的西非黑人為Duffy抗原陰性血型, 而間日瘧原蟲裂殖子在紅細胞膜上的受體是Duffy血型抗原,裂殖子入侵紅細胞需要Duffy血型物質作為受體,Duffy血型陰性者紅細胞膜上無此受體,因而間日瘧原蟲不能入侵紅細胞。由遺傳因素造成的鐮狀細胞貧血者,對惡性瘧原蟲不易感。在非洲患鐮狀細胞貧血的兒童其惡性瘧的感染率低於正常兒童,且前者的重症瘧疾及因瘧疾而死亡的比例遠少於後者。這是因為在缺氧條件下紅細胞內鉀離子濃度下降,可造成瘧原蟲死亡;由於鐮狀細胞血紅蛋白較難溶於水,使瘧原蟲的吞噬和胞飲作用發生障礙;在氧分壓較低時血紅蛋白可形成微結晶並刺入瘧原蟲的表膜,從而影響其生存。葡萄糖—6—磷酸脫氫酶(G6PD) 缺乏者對瘧原蟲也具有先天抵抗力,臨床研究證實,G6PD 缺乏的兒童可以免遭重症惡性瘧疾。缺乏者的紅細胞對氧化劑特別敏感,而瘧原蟲的發育需利用宿主細胞內的還原型輔酶II,因此受感染的紅細胞在瘧原蟲成熟前就有自然溶解的傾向。研究先天抵抗力的遺傳因素有助於抗瘧疫苗及抗瘧藥物的開發。相反,地中海貧血者由於其紅細胞內ATP水平較低,有利於瘧原蟲的發育,因此此類患者對瘧原蟲的抵抗力較差,罹患瘧疾時病死率較高。2.獲得性免疫 人體在感染瘧疾後誘導產生有效的免疫。此種免疫為種特異性,對異種瘧原蟲的攻擊基本上無保護作用,此外,還有株和期的特異性,人體對瘧原蟲某一發育期產生的抗性對其他發育期不一定具有抵抗力。
(1)瘧原蟲抗原:瘧原蟲抗原來源於蟲體表面或內部,包括裂殖子形成過程中瘧原蟲殘留的胞漿、含色素的膜結合顆粒、死亡或變形的裂殖子、瘧原蟲空泡內容物及其膜、裂殖子分泌物及瘧原蟲侵入紅細胞時被修飾或脫落的表被物質。種內和種間各期瘧原蟲可能有共同抗原,而另外一些抗原則具有種、期特異性。這些具有種、期特異性的抗原在產生保護性抗體方面可能有重要作用。
來自宿主細胞的抗原不僅包括被瘧原蟲破壞的肝細胞和紅細胞,也包括局部缺血或輔助免疫機制的激活(如補體系統)所破壞的許多其他組織細胞。
(2)體液免疫:體液免疫在瘧疾保護性免疫中有十分重要的作用。當原蟲血症出現後,血清中IgG、IgM和IgA的水平明顯增高,尤以前兩者更甚。但這些Ig中具有對瘧原蟲特異性的抗體只是一小部分。通過單克隆抗體及免疫血清對體外培養的瘧原蟲生長的抑制以及在機體內作被動轉移免疫力的實驗,都可以證明體液免疫對瘧原蟲的重要作用。
抗體可通過下列幾種方式阻止裂殖子侵入紅細胞:補體介導損害裂殖子;空間上干擾對紅細胞配體的識別以影響侵入過程;阻止表面蛋白成熟;裂殖體破裂時,通過凝集裂殖子阻止其釋放。
(3)細胞介導免疫:瘧疾感染過程中,細胞介導免疫具有重要的作用。細胞介導免疫主要包括單核吞噬細胞、T細胞和自然殺傷細胞,以及由這些細胞分泌的細胞因子,如IFN-γ、TNF等。
總之,抗瘧疾的免疫機制十分複雜,非特異性與特異性免疫互為條件、相互補充,體液與細胞免疫相互調節、相互平衡,瘧原蟲抗原與宿主的MHC之間的相互關係等都可能對機體的免疫過程及其後果產生影響,很多問題還有待深入研究。
(4)帶蟲免疫及免疫逃避:人類感染瘧原蟲後產生的免疫力,能抵抗同種瘧原蟲的再感染,但同時其血液內又有低水平的原蟲血症,這種免疫狀態稱為帶蟲免疫(premunition)。通過被動輸入感染者的血清或已致敏的淋巴細胞給易感宿主,可使之對瘧原蟲的感染產生抵抗力,這說明機體有特異性抑制瘧原蟲在紅細胞內的發育的免疫效應。
宿主雖有產生各種體液免疫和細胞免疫應答的能力,以抑制瘧原蟲的發育增殖,但瘧原蟲也有強大的適應能力來對抗宿主的免疫殺傷作用。瘧原蟲逃避宿主免疫攻擊的機制十分複雜,與之有關的主要因素包括下列幾個方面:
1)寄生部位:不論紅細胞外期或紅細胞內期的瘧原蟲,主要在宿主細胞內生長發育以逃避宿主的免疫攻擊。
2)抗原變異(antigenic variation)和抗原多態性(polymorphism):即與前身抗原性稍有改變的變異體。諾氏瘧原蟲在慢性感染的猴體內每次再燃都有抗原變異。大量證據說明在同一瘧原蟲蟲種記憶體在著許多抗原性有差異的株。
有效的免疫反應常受到高度多態性抗原的制約。幾種瘧原蟲蛋白質序列多態性很常見,特別是有廣泛重複區的蛋白,例如環子孢子蛋白(CSP),該抗原能下調抗體成熟和高親和力抗體產生;惡性瘧裂殖子表面蛋白-1(MSP-1)可以誘導MSP-1的“阻斷抗體”,這種抗體可以阻止任何有抑制能力抗體的連線。
3)改變宿主的免疫應答性:患急性瘧疾時,機體的免疫應答性和淋巴細胞亞群在外周血液、脾和淋巴結中的分布都有明顯改變。一般均有T細胞的絕對值減少,B細胞相對值增加,與此同時,表現有免疫抑制、多克隆淋巴細胞活化,毒殺淋巴細胞抗體(lymphocytotoxic antibody)及可溶性循環抗原等。
(5)瘧疾疫苗:瘧疾疫苗的研究在最近的30年中仍取得了明顯的成果。已研製出了一系列針對瘧原蟲生活史各期的侯選疫苗。瘧疾疫苗可分為子孢子疫苗(抗感染疫苗)、肝期疫苗(抗紅細胞外期疫苗)、無性血液期疫苗(抗紅細胞內期疫苗和抗裂殖子疫苗)和有性期疫苗(傳播阻斷疫苗)等。
由於瘧原蟲抗原蟲期多且抗原成分複雜,因此單一抗原成分的疫苗免疫效果較差。多蟲期多抗原複合疫苗是目前研究的重點,其中有些已取得令人鼓舞的結果,如利用瘧原蟲CS段重複序列的B細胞表位和非重複區的輔助T細胞表位組成的多抗原系統(MASP)免疫動物後能產生較高的保護性免疫力,但離實際套用還有一段距離。
二.媒介按蚊對瘧原蟲的免疫 按蚊(Anopheles)是瘧疾的傳播媒介,不但為瘧原蟲在蚊體內的配子生殖和孢子生殖提供了必要的內環境和相關因子,而且按蚊的免疫系統也對瘧原蟲的發育和繁殖發揮抑制作用。蚊吸血時,通常有大量的配子體隨血餐進入蚊胃,但是蚊胃內的瘧原蟲受按蚊的免疫攻擊,只有約1/10~1/20的能發育成動合子,當動合子穿過蚊胃上皮細胞後,只有極少數卵囊成熟,孢子生殖產生大量的子孢子釋放到蚊血淋巴中,但能在唾液腺內發育成感染性子孢子的也只有很少一部分。由此可見,按蚊的免疫系統能抑制瘧原蟲的發育。按蚊對瘧原蟲的殺滅作用主要是通過黑化包被反應進行的,此外,受染按蚊產生的NO和抗菌肽也對瘧原蟲在蚊體內的發育具有一定的抑制作用。
黑化包被反應是一種體液性黑化反應 (humoral melanization)。與其它昆蟲一樣,按蚊的黑化反應是由前酚氧化酶級聯反應 (prophenoloxidase cascade)介導引起的。通過激活前酚氧化酶活化酶,使前酚氧化酶轉變成有活性的酚氧化酶(phenoloxidase,PO),然後,PO羥化單酚氧化酶並氧化雙酚氧化酶,產生大量的醌類中間產物聚合形成黑色素。這些黑色素協同具有細胞毒性的醌類中間產物沉積到入侵的病原體周圍,起到隔離殺死病原體的作用,即黑化包被反應。
實驗診斷
1.病原學診斷 厚、薄血膜染色鏡檢是目前最常用的方法。從受檢者外周血液中檢出瘧原蟲是確診的最可靠依據,最好在服藥以前取血檢查。取外周血製作厚、薄血膜,經姬氏或瑞氏染液染色後鏡檢查找瘧原蟲。薄血膜中瘧原蟲形態完整、典型,容易識別和鑑別蟲種,但原蟲密度低時,容易漏檢。厚血膜由於原蟲比較集中,易檢獲,但染色過程中紅細胞溶解,原蟲形態有所改變,蟲種鑑別較困難。因此,最好一張玻片上同時製作厚、薄兩種血膜,如果在厚血膜查到原蟲而鑑別有困難時,可再檢查薄血膜。惡性瘧在發作開始時,間日瘧在發作後數小時至10餘小時採血能提高檢出率。2.免疫學診斷
(1)循環抗體檢測:常用的方法有間接螢光抗體試驗、間接血凝試驗和酶聯免疫吸附試驗等。由於抗體在患者治癒後仍能持續一段時間,且廣泛存在著個體差異,因此檢測抗體主要用於瘧疾的流行病學調查、防治效果評估及輸血對象的篩選,而在臨床上僅作輔助診斷用。
(2)循環抗原檢測:利用血清學方法檢測瘧原蟲的循環抗原能更好地說明受檢對象是否有活動感染。常用的方法有放射免疫試驗、抑制法酶聯免疫吸附試驗、夾心法酶聯免疫吸附試驗和快速免疫色譜測試卡 (ICT)等。
3.分子生物學技術 PCR和核酸探針已用於瘧疾的診斷,分子生物學檢測技術的最突出的優點是對低原蟲血症檢出率較高。用核酸探針檢測惡性瘧原蟲,其敏感性可達感染紅細胞內0.0001%的原蟲密度。國內學者採用套式 PCR技術擴增間日瘧原蟲 SSU rRNA基因120bp的特定片段,其敏感性達0.1原蟲/μl血。
流行病學
1.流行概況 瘧疾是嚴重危害人類健康的疾病之一,據世界衛生組織(WHO)統計,目前世界上仍有90多個國家為瘧疾流行區,全球每年發病人數達3億~5億,年死亡人數達100萬~200萬,其中80 %以上的病例發生在非洲。建國前,我國瘧疾流行嚴重,流行地區可分為四類:
(1)高瘧區:在北緯25°以南,即南嶺山脈以南地區,是我國瘧疾流行最嚴重的地區。除間日瘧、惡性瘧和三日瘧外,卵形瘧也偶有報導。惡性瘧和混合感染比例均高。
(1) 穩定中瘧區和低瘧區:在北緯25~33°之間,即南嶺山脈和秦嶺、淮
河之間地區。以間日瘧為主,兼有惡性瘧,常有暴發流行。
(2) 非穩定低瘧區:北緯33°以北,即秦嶺、淮河以北地區,瘧疾流行相
對較輕,間日瘧原蟲為唯一蟲種,但亦有因惡性瘧輸入而引起的流行。
(4)天然無瘧區:包括青藏高原、西北、內蒙的荒漠和東北林區。新疆伊犁河流域和南疆少部分地區僅有少數間日瘧發生。
據不完全統計,20世紀40年代我國每年至少有3000萬以上瘧疾患者,病死率約為1%。50年代初期,全國有瘧疾流行的縣(市)計1,829個,占當時縣(市)總數的70%~80%。
隨著抗瘧工作進展,惡性瘧流行範圍逐漸縮小,1995年後除海南、雲南兩省仍有惡性瘧流行外,其餘各省、自治區、直轄市已無惡性瘧傳播。瘧疾病死率已由1950年的0.49%下降至1998年的0.08%。 1996~1998年全國瘧疾發病降至3萬餘例,但2000年疫情出現回升,發病人數為26.6萬,尤其在我國中部地區的蘇、豫、皖、鄂等省曾出現過局部暴發流行。
人群帶蟲率是反映瘧疾流行程度的一個重要指標。50年代南部和西南部各省、自治區居民帶蟲率一般在10%~20%,高的達50%以上,中部地區人群帶蟲率一般為5%~10%。經過多年大規模抗瘧,人群帶蟲率逐年降低。1991~1998年對監測點居民、學生、流動人口等重點人群共血檢484.8萬人次,除了海南、雲南兩省人群帶蟲率尚在1%~3%外,其餘各省、自治區、直轄市均在1%以下。
2.流行環節
(1)傳染源:外周血中有配子體的患者和帶蟲者是瘧疾的傳染源。間日瘧原蟲的配子體常在原蟲血症2~3天后出現,惡性瘧原蟲配子體在外周血中出現較晚,要在原蟲血症後7~11天才出現,血中帶紅細胞內期瘧原蟲的獻血者也可通過供血傳播瘧疾。
(2)傳瘧媒介:按蚊是瘧疾的傳播媒介,我國主要的傳瘧按蚊是中華按蚊、嗜人按蚊、微小按蚊和大劣按蚊。
(3)易感人群:除了因某些遺傳因素對某種瘧原蟲表現出不易感的人群及高瘧區嬰兒可從母體獲得一定的抵抗力外,其他人群對人瘧原蟲普遍易感。反覆多次的瘧疾感染可使機體產生一定的保護性免疫力,因此瘧區成人發病率低於兒童,而外來的無免疫力的人群,常可引起瘧疾暴發。
瘧疾的流行除需具備上述三個基本環節外,傳播強度還受自然因素和社會因素的影響。自然因素中溫度和雨量最為重要,適合的溫度和雨量影響著按蚊的數量和吸血活動及原蟲在按蚊體內的發育。全球氣候變暖,延長了蟲媒的傳播季節是疫情回升的原因之一。社會因素如政治、經濟、文化、衛生水平及人類的社會活動等直接或間接地影響瘧疾的傳播與流行。近年來,我國有些地區疫情上升,其主要原因是經濟開發後流動人口增加,輸入病例增多,引起傳染源擴散。
防治
1946年DDT殺滅成蚊的試驗取得成效後,使得消滅瘧疾成為可能,1955年第8屆世界衛生大會把以前的控制瘧疾策略改為消滅瘧疾策略,隨著時間的推移,人們發現利用殺蟲劑消滅媒介按蚊面臨著越來越多的問題,諸如耐藥蚊種的出現,殺蟲劑造成的環境污染以及生態平衡等問題,終使全球滅瘧規劃受到嚴重挫折。1978年第31次世界衛生大會決定放棄全球限期滅瘧的規劃,把對瘧疾的防治對策改回到控制的策略。20年間經歷的這兩次策略大轉變,不僅反映了瘧疾問題的複雜性,同時亦體現人們對瘧疾作鬥爭的認識在不斷提高。我國目前的瘧疾防治策略是執行“因地制宜、分類指導、突出重點”的方針,採取相對應的綜合性防治措施,堅持長期作戰,反覆鬥爭。在以中華按蚊為唯一媒介的廣大地區,採取以防治傳染源和防蚊為重點,結合減少村內外蚊蟲孳生地的綜合措施。在微小按蚊、嗜人按蚊為主要媒介的地區,採取滅蚊和防治傳染源並重的措施。在大劣按蚊為主要媒介的地區,採取以改變生態環境、防制傳播媒介為主、結合傳染源防治的綜合措施。在發病率已降至1/萬以下的基本消滅瘧疾的地區,採取以瘧疾監測為主的措施。
1.預防 包括個體預防和群體預防。預防措施有蚊媒防制和預防服藥。蚊媒防制包括殺滅蚊和使用蚊帳及驅蚊劑。預防服藥是保護易感人群的重要措施之一。常用的預防性抗瘧藥有氯喹(chloroquine),對抗氯喹的惡性瘧,可用哌喹(piperaquine)或哌喹加乙胺嘧啶(pyrimethamine)或乙胺嘧啶加伯氨喹啉(primaquine)。不論個體或群體進行預防服藥,每種藥物療法不宜超過半年。
2.治療:瘧疾治療應包括對現症病人的治療(殺滅紅細胞內期瘧原蟲)和瘧疾發作休止期的治療(殺滅紅細胞外期休眠子)。休止期的治療是指在瘧疾傳播休止期,對1~2年內有瘧疾史和帶蟲者的治療,以控制間日瘧的復發和減少傳染源。
按抗瘧藥對瘧原蟲不同蟲期的作用,可將其分為殺滅紅細胞外期裂子體及休眠子的抗復發藥,如伯氨喹啉;殺滅紅細胞內裂體增殖期的抗臨床發作藥,如氯喹、咯萘啶(pyronaridine)、青蒿素(artmisinin)類和殺滅子孢子抑制蚊體內孢子增殖的藥,如乙胺嘧啶。
對現症患者,可用氯喹加伯氨喹啉,以治療瘧疾疑似患者或間日瘧;抗間日瘧復發(休止期治療)可用伯氨喹啉加乙胺嘧啶、青蒿琥酯加伯氨喹啉效果更佳;惡性瘧可單服氯喹,抗氯喹的惡性瘧則宜聯合用藥,如哌喹加磺胺多辛(sulfadoxine)、咯萘啶加磺胺多辛及伯氨喹啉、複方蒿甲醚片等,單用青蒿琥酯、蒿甲醚、雙氫青蒿素等也有一定療效;重症瘧疾(如腦型瘧)首選青蒿素類藥物,如蒿甲醚油劑肌注、青蒿琥酯鈉靜注、或靜注雙氫青蒿素加二鹽酸喹啉;此外,青蒿素類藥物的栓劑適用於不能口服藥物的患者。上述各種抗瘧藥物必須足量並服完全程才能達根治瘧疾的目的。
